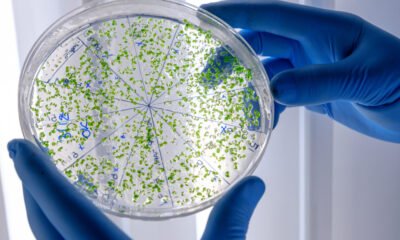
Fatos científicos pouco conhecidos que surpreendem

Postagens
-


Curiosidades
/ 2 meses atrásComo funciona a internet: guia simples e completo
Como funciona a internet parece mágica, porém é um conjunto de regras e equipamentos que transportam dados entre computadores no mundo...
-


Curiosidades
/ 2 meses atrásComo funcionam os algoritmos na prática
Como funcionam os algoritmos é uma dúvida comum, porque eles parecem “mágicos”, porém são apenas instruções organizadas para resolver tarefas com...
-


Curiosidades
/ 2 meses atrásComo funciona a inteligência artificial de forma simples
Como funciona a inteligência artificial parece complicado, porém começa com a ideia simples de máquinas reconhecerem padrões e tomarem decisões a...
-


Curiosidades
/ 2 meses atrásComo funcionam os motores de busca: guia definitivo
Como funcionam os motores de busca é uma curiosidade frequente, porque parece que o Google “adivinha” o que queremos, mesmo com...
-


Ciência
/ 2 meses atrásComo o cérebro aprende coisas novas na prática
Como o cérebro aprende coisas novas envolve neuroplasticidade, memória e prática, pois o aprendizado é uma mudança física e funcional nas...
-


Ciência
/ 2 meses atrásComo a ciência explica emoções humanas
Como a ciência explica emoções é uma pergunta recorrente, pois sentimentos parecem subjetivos, mas surgem de processos biológicos mensuráveis que acontecem...
-


Ciência
/ 2 meses atrásDescobertas científicas importantes que mudaram a vida
Descobertas científicas importantes mudaram a vida humana ao transformar doenças, energia, comunicação e alimentação, além de alterar como entendemos nosso próprio...
-

Ciência
/ 2 meses atrásFatos científicos pouco conhecidos que surpreendem
Fatos científicos pouco conhecidos aparecem até em situações comuns, porém passam despercebidos porque o cérebro prefere explicações rápidas, mesmo quando estão...
-


Curiosidades
/ 2 meses atrásCoisas que a maioria das pessoas não sabe
Coisas que a maioria das pessoas não sabe despertam curiosidade imediata, pois revelam fatos escondidos em situações comuns do dia a...
-


Ciência
/ 2 meses atrásCoisas que fazemos todos os dias e não entendemos
Coisas que fazemos todos os dias e não entendemos fazem parte da rotina, pois muitas ações são automáticas e raramente paramos...













